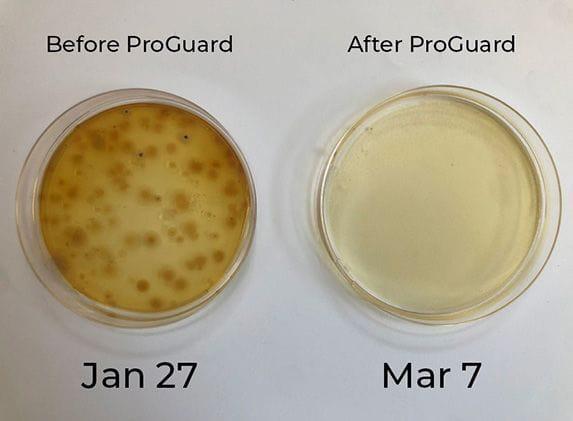
The Hydro Bros
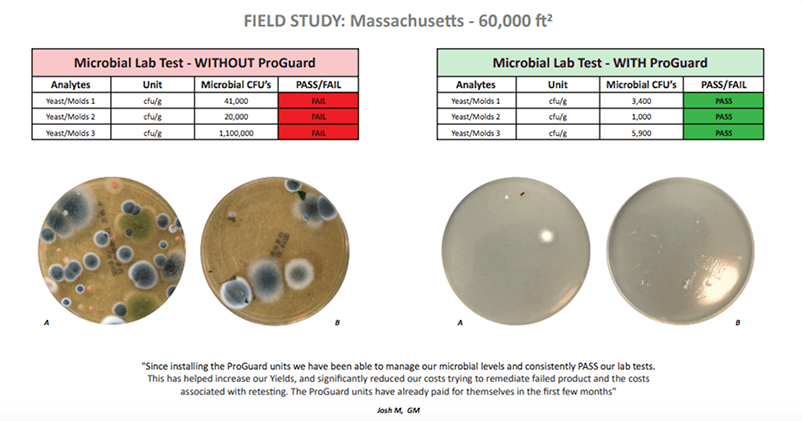
The Hydro Bros

Description
The ProGuard Defender DXB Mini (25 m² coverage) with BPI technology is designed to deliver continuous air and surface sanitisation in high-load environments such as greenhouses and grow rooms. Using advanced ProGuard Sanitization Technology, it helps reduce and eradicate airborne and surface pathogens for a cleaner, safer grow environment.
Manual / Installation Instructions
How It Works
ProGuard technology is widely used in commercial cultivation environments where microbial control is essential for compliance. The system actively releases powerful sanitisers that seek out and neutralise mould spores, mildew, bacteria, and harmful pathogens—both in the air and on surfaces such as benches, lights, and ducting. The result is 24/7 protection that maintains a cleaner room environment and a healthier crop.
Why Air Sanitisation Matters
Grow rooms are naturally high-humidity spaces, making them prone to powdery mildew, mould, and other pathogens that can quickly destroy a crop. An air sanitiser adds a crucial layer of protection by targeting airborne contaminants before they settle and spread.
- Powdery mildew spores can travel easily via airflow, ventilation systems, or even clothing and tools.
- They can remain dormant until humidity and temperature conditions become ideal for rapid growth.
- Mildew suppresses photosynthesis, reducing nutrient uptake and slowing plant development.
- All plant stages are vulnerable — seedlings, clones, veg, and flowering plants.
- Many fungicidal sprays impact crop quality or fail regulatory testing, making air sanitisation a safer alternative.
- Contaminated crops risk failing mould and microbial safety standards.
In short, an air sanitiser is one of the most effective defences against costly contamination in controlled environments.
The ProGuard Difference
Unlike systems that rely on chemical additives or ozone, ProGuard’s patented Active Sanitization Distribution uses photocatalytic oxidation (PCO) technology. UV energy interacts with a proprietary catalyst to transform ambient moisture into a mild hydrogen peroxide vapour that circulates through the space, neutralising up to 99.9% of airborne and surface pathogens.
This continuous sanitisation process significantly reduces mould, mildew, bacteria, and VOCs — promoting a cleaner, more stable growing environment and helping crops pass microbial compliance testing.
Coverage & Power
The DXB Mini is suited for grow and dry rooms up to approximately 25 m² (250 sq ft) and can also be used in smaller adjoining spaces such as hallways or processing areas. Power draw is minimal, operating between 14–22W, allowing for efficient 24/7 use.
Reliability & Maintenance
Each DXB Mini is easy to install, runs continuously, and requires minimal maintenance. The system has been tested and validated by independent laboratories worldwide for safety and effectiveness in reducing mould, bacteria, and viruses in indoor grow environments.
Specifications
- Coverage: Up to 25 m² (250 sq ft)
- Weight: 2.75 lbs
- Dimensions (H × L × D): 10” × 10” × 4”
- Input Voltage: 100–240V AC (50/60Hz)
- Output: 12V DC, 3A
- Power Consumption: 14–22W
- Warranty: 2 years
When you compare the cost of losing an entire crop to the cost of prevention, the DXB Mini pays for itself quickly.